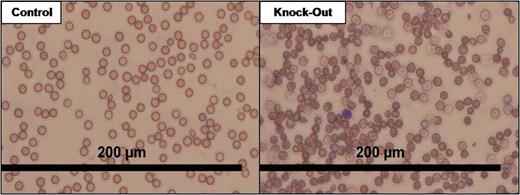
graphic

Abstract
Abstract 1991
Poster Board I-1013
Sideroblastic anemia is caused by an inappropriate incorporation of iron into hemoglobin, and as such a phenotype demonstrating ringed sideroblasts, improper iron deposition, and malignancy is observed. The only known hereditary cause of this disease is a mutation in delta-aminolevulinate synthase 2 (ALAS2), which is a mitochondrially located enzyme that catalyzes the first step in heme synthesis, while the causes of the acquired or idiopathic forms remain unknown. With the knowledge that the free radical superoxide (O2•-) is able to displace iron from heme-containing proteins, it is hypothesized that the loss of the mitochondrial anti-oxidant enzyme manganese superoxide dismutase (MnSOD), encoded by the SOD2 gene, may cause disruption of proper heme synthesis and as such may contribute to a sideroblastic anemia-like phenotype. Methods: Due to the early lethality of the constitutive MnSOD knock-out mouse, a floxed (flanked by loxP) MnSOD mouse was created. Homozygous hematopoietic stem cell specific SOD2 knock-outs were generated by breeding the floxed MnSOD mice with mice expressing Cre-recombinase under the control of the hematopoietic stem cell specific promoter Vav. Results: Mice harboring the hematopoietic knock-out of MnSOD are born viable, and are able to live to maturity. Complete blood count (CBC) analysis of knock-out mice demonstrated a decrease in red blood cells (RBC), thymic white blood cells, and splenic white blood cells. The knock-outs additionally showed a decrease in hemoglobin to 5 g/dL compared to 11 g/dL in controls, a reduction in hematocrit to 32% versus 43.5% in controls, and a reticulocyte count of 31.6% compared to only 7.9% in controls. CBC analysis also revealed many RBC morphology flags including hypochromasia, ansiocytosis, and hematocrit variance. These findings were visualized in blood smears (see below). Finally, electron paramagnetic resonance spectrometry of plasma from the knock-out mice showed a ∼2-fold decrease in transferrin levels compared to controls. Conclusions: The loss of MnSOD in the hematopoietic stem cell population of a mouse creates a viable organism, but with an apparent sideroblastic anemia phenotype. Additionally, the white blood cells within these organisms also may be affected due to the decrease in total cellularity, and thus could contribute to immunodeficiency and/or malignancy later in the animal's life. Overall, this phenotype is very comparable to those observed in human patients, and as such MnSOD may play an undiscovered role in acquired or idiopathic sideroblastic anemia. Future work will focus on further characterization of the animals, examination of human blood samples for MnSOD mutations, and the use of SOD mimetics to potentially reverse the observed phenotype. This work was supported by NIH grants CA73612 and CA115438
No relevant conflicts of interest to declare.
Author notes
Asterisk with author names denotes non-ASH members.
This feature is available to Subscribers Only
Sign In or Create an Account Close Modal